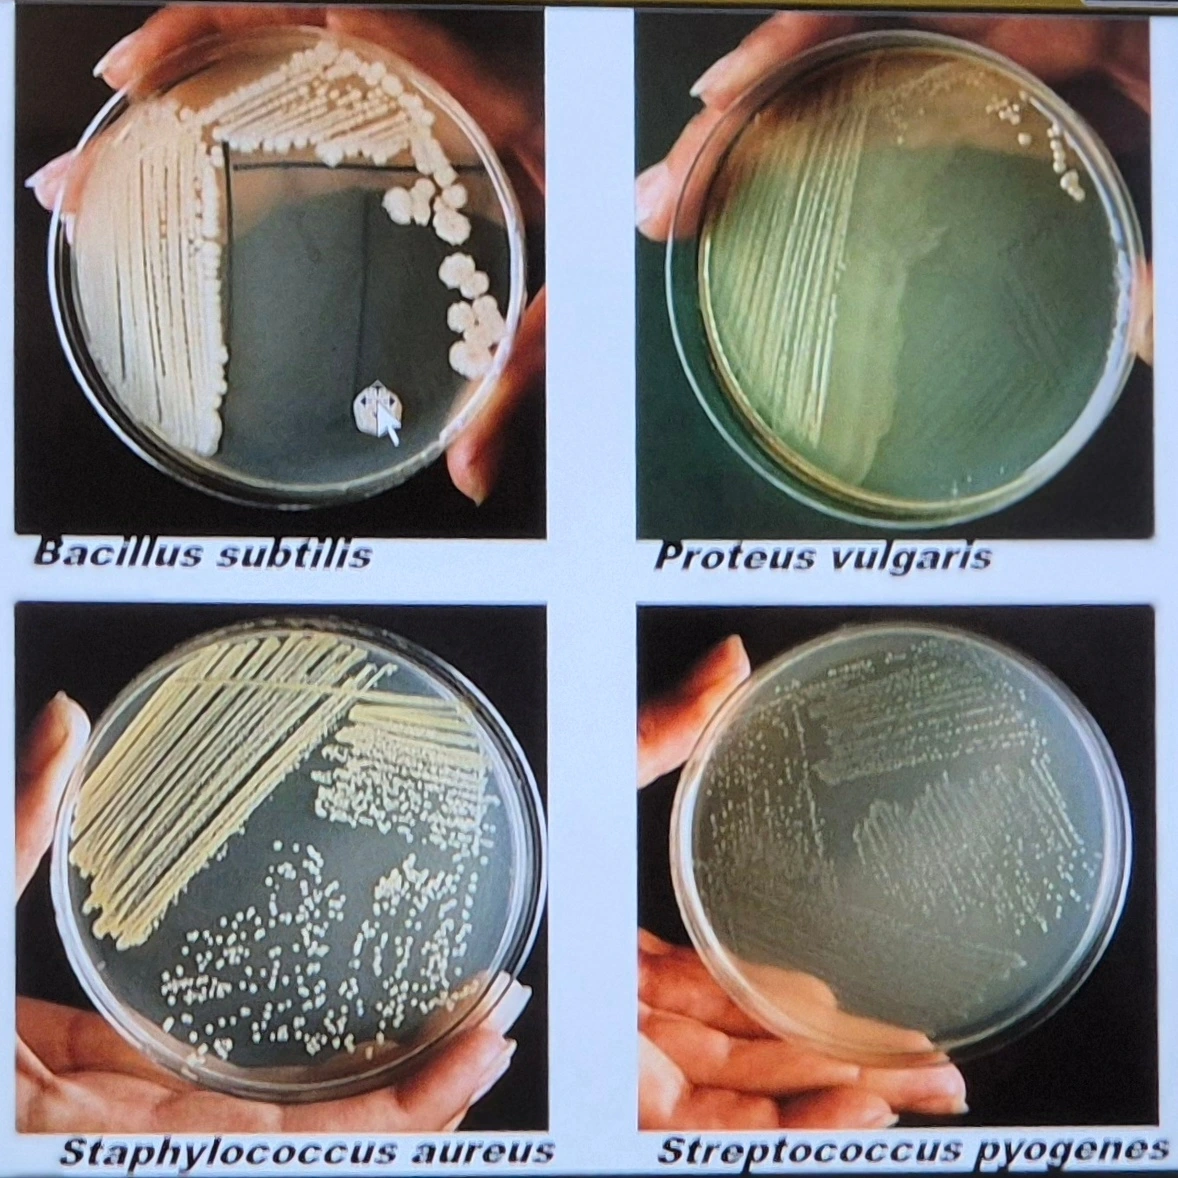
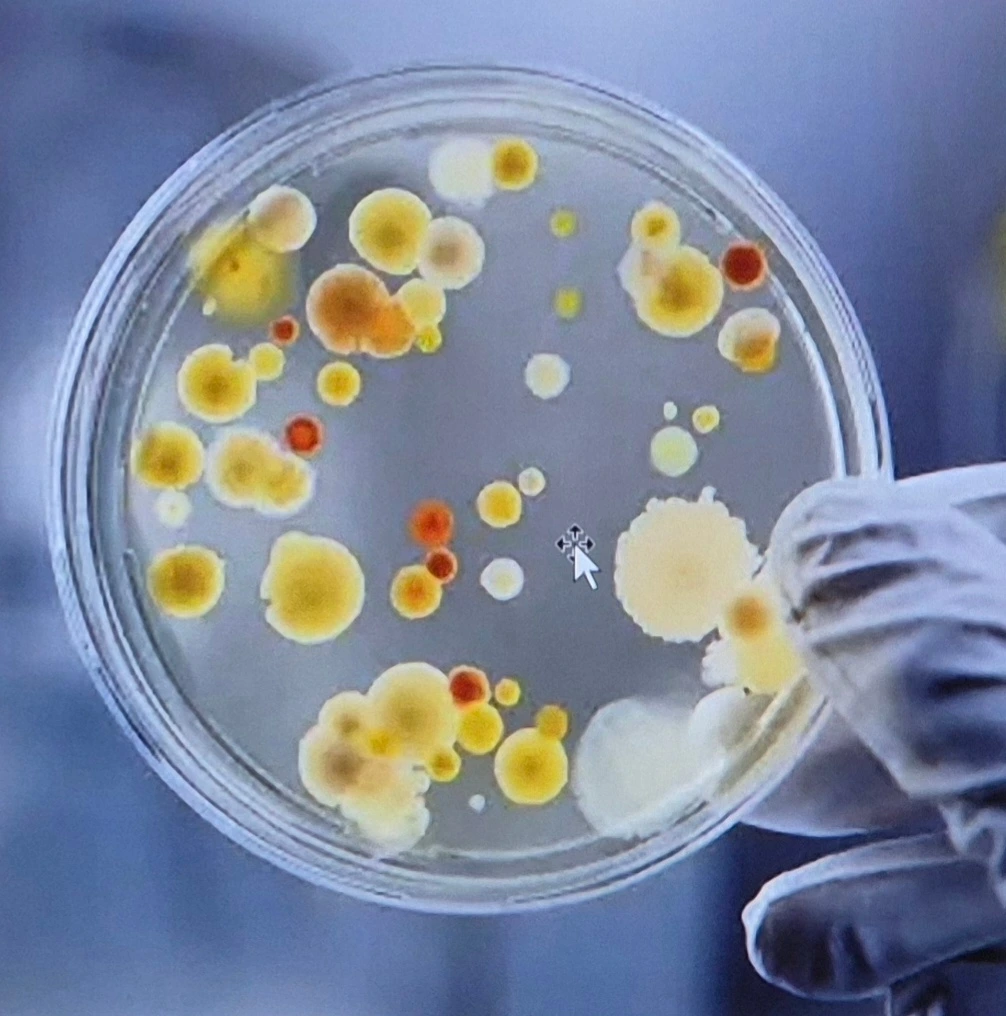

미생물의 얼굴
57노송포럼의 밤에 생각한 것들
미생물의 얼굴: 57노송포럼의 밤에 생각한 것들
- 성균관대 의대 한명준 교수 강연
 성균관대 의대 미생물학 교실 한명준 교수
성균관대 의대 미생물학 교실 한명준 교수 매월 셋째 주 수요일, 우리는 고교 동창들이 번갈아가며 강의를 맡는 57노송포럼에 모인다.
성실함이 체질처럼 몸에 배어 있는 총무 S가 준비한 저녁 도시락은 늘 탁월하다. 한 달 동안 밀린 정담을 나누는 평범한 저녁 시간이지만, 이상하게도 이 시간이 닿으면 모두의 마음이 따뜻해진다.
오늘은 특히 그렇다. 우리가 오래전부터 흥미롭게 지켜보던 주제, ‘미생물(microbe)’에 대한 강의가 준비되어 있었기 때문이다. 강의 제목은 단순했지만, 숨겨진 부제는 분명 이랬을 것이다.
“미생물은 친구인가, 적인가?”

- 세균과 바이러스, 그 오래된 미스터리
한명준 교수는 늘 그렇듯 담담한 어조로 질문을 던졌다.
“세균과 바이러스의 차이를 아시나요?”
미생물은 눈에 보이지 않는 작은 존재들이다.
세균, 바이러스, 기생충, 곰팡이, 아메바, 그리고 논란을 부르는 프리온까지.
그 가운데 특히 바이러스는 스스로 대사조차 하지 못해 “생명체인가 아닌가”라는 질문을 100년째 부르고 있다.

바이러스의 크기는 고작 20~200 나노미터.
그 작은 존재가 세포로 들어가 핵을 장악하고 RNA와 DNA를 복제한다.
어떤 바이러스는 아예 세균에 감염되어 세균을 죽게 만들기도 한다.
도표 속 박테리오파지는 마치 우주선처럼 생긴 모습으로, 그저 세균을 ‘주입’하는 데 인생을 건다.

“CAR-T 치료도 결국 바이러스의 작동 원리를 이용합니다.”
한 교수의 말은 아주 현대적이면서도 무겁게 들렸다.
CAR-T는 인간이 만든 인공 리셉터를 환자의 T세포에 넣어 암을 공격하게 하는 기술이다.
아직 우리나라에서는 보험이 적용되지 않지만 일부 암에서는 이미 표준 치료처럼 쓰인다.
 CAR-T: Chimeric Antigen Receptor T-cell
CAR-T: Chimeric Antigen Receptor T-cell 그 순간, 그는 자신의 경험을 풀어놓았다.
- 한 가족의 병상, 항생제의 절박함
20년 전, 한 교수의 배우자는 백혈병으로 병원에 누워 있었다. 강력한 방사선으로 치료한 뒤 찾아온 가장 위험한 적은 감염이었다.
방코마이신에도 내성을 가진 세균에 감염되며 혈압이 급강하했고, 새벽 응급실은 위급상황이 되었다.
그는 감염내과 의사 친구에게 긴급 전화를 걸어 프랑스 신약 항생제를 구해 가까스로 위기를 넘겼다고 했다.
그의 목소리는 담담했지만, 그 순간의 공포는 모두에게 전달됐다.
항생제 내성은 더 이상 연구실의 논문이 아니라, 사람의 생명을 빼앗는 눈앞의 현실이었다.

- 미생물학의 긴 역사, 그리고 침묵하던 존재들의 이름
1674년 루벤훅이 현미경으로 미생물을 처음 관찰한 이후 과학은 서서히, 그러나 집요하게 이 세계를 밝히기 시작했다.
1876년 로버트 코흐는 탄저병의 원인을 밝혀내며 ‘감염 병원체’라는 개념을 정립했다.
1928년 플레밍은 페니실린을 발견해 2차 대전에서 수많은 생명을 구했다.
그러나 1960년대 들어 페니실린 내성이 폭발하듯 증가하며 인류는 다시 새로운 전쟁을 준비해야 했다.

호주의 마샬과 워런은 H. pylori를 찾아내 위궤양의 원인이 ‘위산과 스트레스’뿐만이 아니라 세균에도 있다는 것을 입증했다. 그들은 2005년에 노벨생리의학상을 수상했다. 마샬이 직접 세균을 삼키고 자기 몸에 위궤양을 만든 뒤 항생제로 치료하며 입증한 사실은 세상을 놀라게 했었다.


지금은 유전체 분석 기술이 폭발적으로 발달해 6개월 걸리던 작업이 하루 이틀이면 가능하다.
세균만 해도 4만 3천 종이 이름 붙여졌고, 그보다 훨씬 많은 미지의 종들이 깊은 바다, 땅 속, 우리 몸속에서 살아간다.

병을 일으키는 세균은 일부일 뿐이다.
오히려 우리를 지키고, 대사와 면역을 조절하는 세균들이 훨씬 많다.
세균은 주로 대장, 입, 피부, 부비강, 목구멍. 여성의 질 등에 분포한다.

- Microbiota, Microbiome: ‘나’라는 존재의 확장
이제 과학자들은 말한다.
Microbiota: 그 공간에 살고 있는 미생물
Microbiome: 그들의 유전체와 대사산물까지 포함한 전체 생태계

즉, 인간은 인간 혼자가 아니라, 세균, 고균, 진핵생물 등 또다른 자아와 함께 사는 Holobiont(홀로바이온트)에 가깝다. 프랑스의 구조주의자들이 말하던 “타자의 나" 혹은 불교에서 말하는 “무아(無我)”에 닿는 개념이 사이언스의 얼굴을 하고서 마이크로바이옴을 바라보는 시각이다.
나는 내가 아니다.
나는 나와 함께 사는 수십조 미생물들의 공동체다.

- 비만은 미생물의 문제였을까?
강의 후반, 한 교수는 흥미로운 이야기를 꺼냈다. 비만도 미생물과 관련이 있을 수 있다는 것이었다.
2006년 제프리 고든의 연구.
비만 쥐와 마른 쥐를 비교했더니 장내미생물의 구성이 달랐다.
비만 → Firmicutes ↑, Bacteroidetes ↓
마름 → Bacteroidetes ↑
심지어 이 미생물 구성만 바꿔도 몸무게가 달라졌다.

그리고 결정적으로, Akkermansia muciniphila(아커만시아)라는 유익균의 존재 여부가 체중과 혈당을 좌우했다.
마른 사람: 약 4%
비만인: 0%에 가까움

아커만시아는 장 점액층을 강화시키고 LPS 흡수를 막아 염증을 줄인다.
당뇨병 약인 메트포르민을 먹인 비만 쥐의 혈당이 좋아지는 이유 가운데 하나도 아커만시아 증가 때문이라는 연구가 있다.

식이섬유를 먹으면 아커만시아가 늘어난다는 사실은 우리 모두를 순간 조용하게 만들었다.
우리가 평생 믿어온 “먹는 양과 운동량”이라는 단순 공식이 어쩌면 미생물의 세계 앞에서는 빙산의 일각일지도 모른다.
- 뇌와 마음도 미생물의 손아귀에 있는가?
최근 연구들은 더 놀랍다.
장내미생물은 자폐증, 우울증, 파킨슨병, 알츠하이머병, 당뇨병, 동맥경화, 천식과 대장암의 발병 가능성까지 조절한다는 보고가 잇따르고 있다.
아직 명확하지 않지만, 세균의 대사산물이 장과 뇌 사이의 긴 신호망을 따라 영향을 준다는 것이다.

한 교수는 조용히 말했지만, 그 말의 무게는 컸다.
“우리의 생각에도 영향을 줄 수 있습니다.”
우리는 모두 서로를 바라보며,
‘정말 그럴까?’
‘이미 시작된 것은 아닐까?’라는 작은 미소를 지었다.
- 마지막 질문: 우리는 누구인가?
오늘의 강의는 단순한 지식 전달이 아니었다.
그것은 우리의 몸, 우리의 정체성, 우리의 생각에 대한 질문이었다.
세균이 생긴 것은 40억 년 전.
그 이후 모든 생명체는 세균의 도움 없이는 살 수 없게 되었다.
우리는 세균과 함께 태어나고, 세균과 함께 늙으며, 세균과 함께 죽는다.
그렇다면 ‘나’라는 존재는 어디까지가 '나'일까?
아마도, 인간은 또 하나의 거대한 미생물 생태계(Holobiont)에 지나지 않을지 모른다. 그 사실을 받아들이는 순간, 세상과 나, 몸과 마음, 건강과 질병을 바라보는 시선이 완전히 달라진다.

- 돌아오는 길에 이런 생각을 했다
57노송포럼의 강의는 늘 그렇듯 우리를 더 나은 곳으로 데려간다. 오늘은 특히 더 그랬다.
보이지 않지만 결정적인 것들,
우리 몸속에 살지만 우리가 모르던 존재들,
그들과 함께 만들어가는 삶의 이야기...
그 작은 존재들을 알게 되는 순간, 우리는 오히려 더 겸손해지고, 더 인간적으로 변한다.
그리고 문득, 이런 질문이 들었다.
“우리는 미생물을 연구하는가,
아니면 미생물이 우리를 연구하는가.”
초겨울의 삭풍이 뇌를 시원하게 훑고 지나갔다.